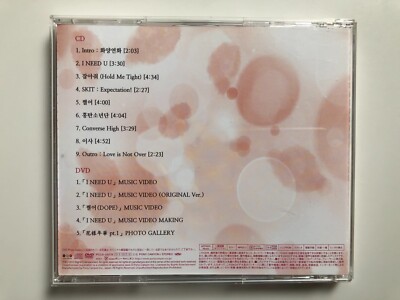
BTS Bangtan Boys Kayo Nenka Pt.1 CD DVD Japan Limited Edition | eBay

マイストア
変更
お店で受け取る
(送料無料)
配送する
納期目安:
2026.02.17 21:21頃のお届け予定です。
決済方法が、クレジット、代金引換の場合に限ります。その他の決済方法の場合はこちらをご確認ください。
※土・日・祝日の注文の場合や在庫状況によって、商品のお届けにお時間をいただく場合がございます。
K-POP・アジア BTS CD+DVD BTS - BTS WORLD TOUR LOVE YOURSELF SPEAK YOURSELF THE FINAL [ DVDの詳細情報
BTS - BTS WORLD TOUR LOVE YOURSELF SPEAK YOURSELF THE FINAL [ DVD。BTS WAKE UP Japanese ver. Type B Japan Limited Edition CD + DVD | eBay。K-POP・アジア BTS NOW 1 K-POP・アジア BTS NOW 1 BTS Now 1 in。BTS FACE YOURSELF初回限定版B.C + CD中に入っているフォトブックなどもおつけします。ANITA MUI 梅艷芳 慾望野獸街 CD。BTS Bangtan Boys Kayo Nenka Pt.1 CD DVD Japan Limited Edition | eBay。バラ売り○開封はしましたが、未使用です。
ベストセラーランキングです
近くの売り場の商品
カスタマーレビュー
オススメ度 4点
現在、3390件のレビューが投稿されています。